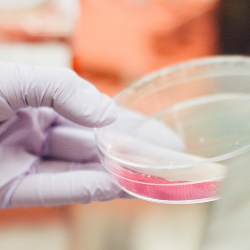

Epilepsi merupakan gangguan pada sistem hantaran listrik otak. Hantaran listrik yang tidak normal dapat menimbulkan perubahan pada pergerakan, perilaku, dan sensasi. Kelompok gangguan epilepsi ditandai dengan kejang berulang. Karena epilepsi disebabkan oleh aktivitas sel otak yang tidak normal, kejang dapat memengaruhi segala aktivitas yang dikendalikan oleh otak. Gejala yang terjadi bergantung pada tipe kejang. Kejang dapat dibedakan menjadi 2 tipe, berdasarkan di bagian otak mana kejang tersebut dimulai, yaitu:
-
Kejang Fokal
Kejang ini berasal dari aktivitas yang tidak normal pada 1 area otak. Kejang fokal bisa dibedakan menjadi kejang fokal tanpa kehilangan kesadaran, yang disebut kejang fokal sederhana, dan kejang fokal yang disertai kehilangan kesadaran, atau disebut kejang fokal kompleks.
-
Kejang Umum
Kejang umum adalah kejang yang melibatkan seluruh bagian otak. Kejang umum dibedakan menjadi 6 tipe, yaitu kejang absans, kejang tonik, kejang atonik, kejang klonik, kejang mioklonik, dan kejang tonik klonik.